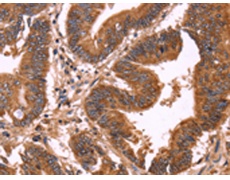
一抗

|
Background: |
This gene encodes a reticuloplasmin, a protein which resides in the lumen of the endoplasmic reticulum (ER). The protein shows sequence similarity to the protein disulfide isomerase family. However, it lacks the thioredoxin motif characteristic of this family, suggesting that this protein does not function as a disulfide isomerase. The protein dimerizes and is thought to play a role in the processing of secretory proteins within the ER. Alternative splicing results in multiple transcript variants encoding different isoforms |
|
Applications: |
ELISA, WB, IHC |
|
Name of antibody: |
ERP29 |
|
Immunogen: |
Synthetic peptide of human ERP29 |
|
Full name: |
endoplasmic reticulum protein 29 |
|
Synonyms: |
ERp28; ERp31; PDIA9; PDI-DB; C12orf8 |
|
SwissProt: |
P30040 |
|
ELISA Recommended dilution: |
2000-5000 |
|
IHC positive control: |
Human colon cancer and Human liver cancer |
|
IHC Recommend dilution: |
50-200 |
|
WB Predicted band size: |
29 kDa |
|
WB Positive control: |
Hela cells and human fetal liver tissue, A549 and 293T cells |
|
WB Recommended dilution: |
500-2000 |


 購物車
購物車 幫助
幫助
 021-54845833/15800441009
021-54845833/15800441009